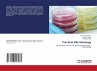
Practical Microbiology - Bild 1

Practical Microbiology
Introductory brochure for laboratory experiments: microbiology
Versandkostenfrei!
Versandfertig in 6-10 Tagen
29,99 €
inkl. MwSt.

PAYBACK Punkte
15 °P sammeln!
The book is a laboratory manual focused on microbiology experiments, specifically related to identifying and characterizing Mycobacterium species, including M. tuberculosis. It includes various tests such as the Neutral Red test, catalase activity, susceptibility to pyrazinamide, amidase test, and nitrate reduction test, detailing the biochemical properties of these bacteria. Furthermore, it discusses bacterial filtration methods, the use of disinfectants like ethanol and isopropanol, and radiation for sterilization. Overall, it serves as a practical guide for students and researchers in micro...
The book is a laboratory manual focused on microbiology experiments, specifically related to identifying and characterizing Mycobacterium species, including M. tuberculosis. It includes various tests such as the Neutral Red test, catalase activity, susceptibility to pyrazinamide, amidase test, and nitrate reduction test, detailing the biochemical properties of these bacteria. Furthermore, it discusses bacterial filtration methods, the use of disinfectants like ethanol and isopropanol, and radiation for sterilization. Overall, it serves as a practical guide for students and researchers in microbiology.